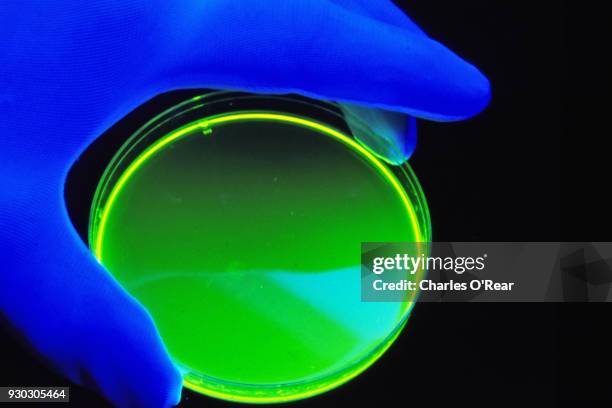
laser dyes - fluorescent dye stock pictures, royalty-free photos & images

46 Images and Stock Photos
View fluorescent dye videos
Browse 46 fluorescent dye photos and images available, or start a new search to explore more photos and images.

of1
Browse 46 fluorescent dye photos and images available, or start a new search to explore more photos and images.


